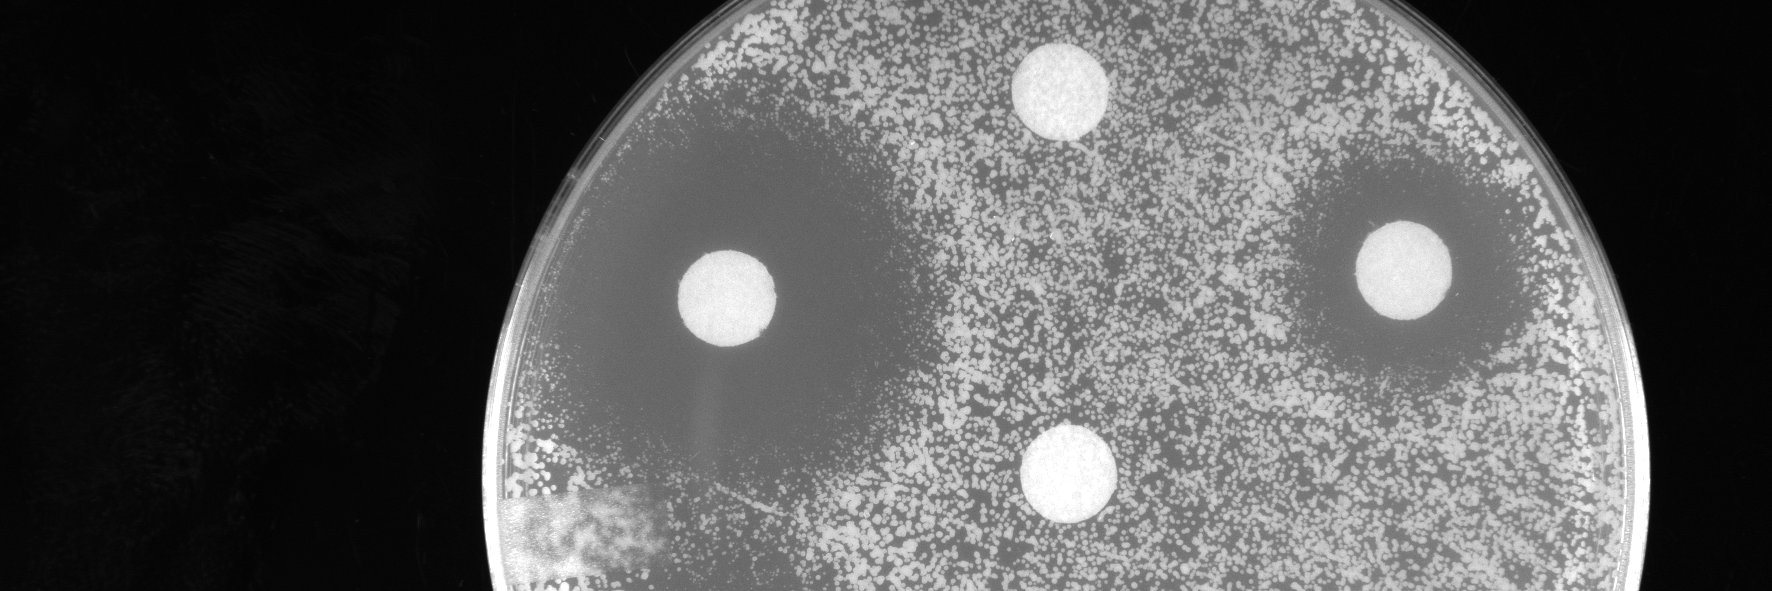
Doug Wassarman banner

What do you do when there's no assay for your protein's activity? Dyes might help! Excited to share protein-adaptive DSF (paDSF), a versatile new dye-based method to create stability assays on-demand. biorxiv.org/content/10.110…
Doug Wassarman
30 posts

@DougWassarman
Biochemist and Chemical Biologist Postdoctoral Research Fellow, Kranzusch Lab Dana-Farber Cancer Institute, Harvard Medical School

What do you do when there's no assay for your protein's activity? Dyes might help! Excited to share protein-adaptive DSF (paDSF), a versatile new dye-based method to create stability assays on-demand. biorxiv.org/content/10.110…





@kevansf & Ziyang Zhang @UCSF describe bifunctional #SmallMolecule ligands of K-Ras that induce its association with immunophilin proteins, #DrugDesign doi.wiley.com/10.1002/anie.2…




UCSF laboratories of @adamrenslo and @mikeevans_ucsf describe a small molecule PET reagent for imaging the disposition of labile ferrous iron in animals. @UCSF @UCSFimaging @ucsfpharmacy pubs.acs.org/doi/full/10.10…





Very happy to say that my illustrated Schlenk line chemistry guide is finally online! Please share with your friends/colleagues/students and let me know what you think! schlenklinesurvivalguide.com #RealTimeChem #SciArt #ChemTwitter


Chemical Biology Comes of Age- it's been great to shepherd our academic chemical biology idea from concept to the clinic over the past twenty years. My hopes have long been for #PROTACs to have a clinical benefit for patients. Good luck @Arvinas! globenewswire.com/news-release/2…

Hot off the press!! Check out the work @KayvonPedram and I did to characterize StcE, a mucin selective protease. Very excited to see this in print!! @CarolynBertozzi #glycotime #PNAS pnas.org/content/early/…